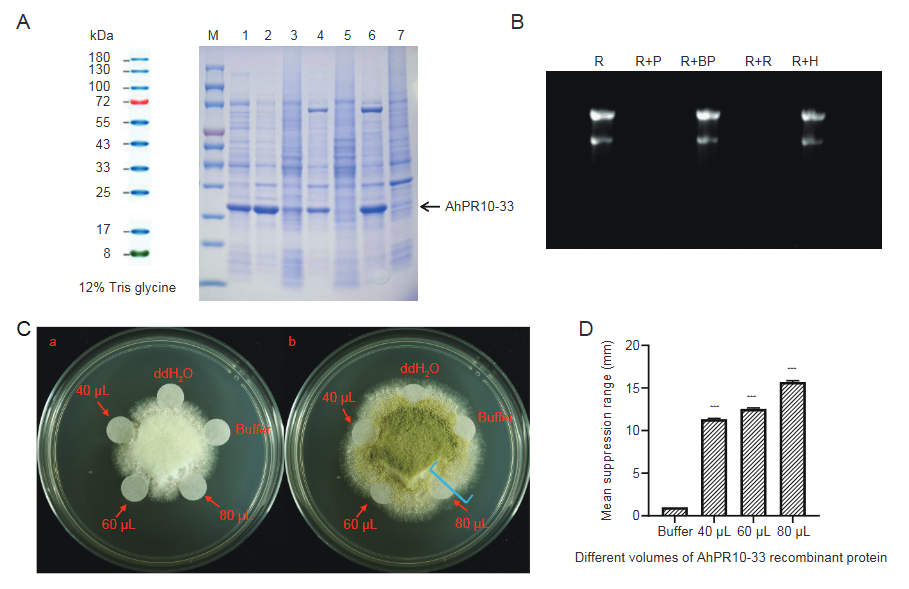
3.png

||
花生(Arachis hypogaea L.)含有大量的油脂和蛋白质等营养物质,在食用植物油消费及休闲食品中占有举足轻重的地位。但花生是最易受黄曲霉菌侵染的作物之一,被侵染后的花生种子会产生强致癌性的黄曲霉毒素,影响花生食用安全,严重危害人类健康。花生生产效益的提高促使其种植面积逐年扩大,然而由于部分产区产后干燥及储藏条件难以保障,花生的黄曲霉毒素污染问题日渐突出。筛选优异的种质资源、选育高抗黄曲霉的优良品种对从源头上解决花生中黄曲霉毒素污染问题至关重要。
发掘黄曲霉抗性关键基因并明确其功能,利用基因工程等生物技术手段有目的地调控抗黄曲霉相关基因的表达,定向培育抗黄曲霉毒素污染的花生新品种是目前从根本上解决黄曲霉毒素污染的理想途径。
近期,河南省农业科学院张新友院士团队完成的题为“Genome-wide characterization and expression analysis of the cultivated peanut AhPR10 gene family mediating resistance to Aspergillus flavus”的研究在Journal of Integrative Agriculture(JIA)2026年1期正式发表。该研究证实了AhPR10-33能够降解黄曲霉菌RNA,具备抵抗黄曲霉菌侵染的能力。
该研究对栽培花生AhPR10基因家族进行了全基因组水平的系统鉴定,并对其系统进化关系、保守基序、基因结构、共线性等进行分析。共鉴定出54个AhPR10基因,基于系统发育分析将其划分为8个不同亚家族,该结果已在基因结构和保守基序的特征分析中得到了证实。染色体分布及共线性分析表明,片段复制事件是AhPR10基因家族扩展的关键。此外,AhPR10基因具有组成型和诱导型两种表达模式。值得注意的是,AhPR10-7、AhPR10-33和AhPR10-41基因可能在花生抵御黄曲霉菌的侵染过程中发挥关键作用。体外抑菌实验表明AhPR10-33融合蛋白能有效抑制黄曲霉菌丝生长。

花生、苜蓿和大豆PR10蛋白家族的系统发育树分析

AhPR10基因的复制基因对及其在染色体上的分布
AhPR10-33重组蛋白核酸酶活性和黄曲霉生长抑制作用分析
综上,这项研究明确了AhPR10-33在花生黄曲霉抗性中的作用,并确定了该基因通过生物育种技术提高花生抵抗黄曲霉侵染的巨大潜能。
河南省农业科学院张新友院士和韩锁义研究员为该文章的共同通讯作者,郑州大学硕士研究生赵琦、河南省农业科学院崔梦杰博士为该文章的共同第一作者。该研究得到了国家重点研发计划和国家自然科学基金的资助。
Cite the article: Qi Zhao, Mengjie Cui, Tengda Guo, Lei Shi, Feiyan Qi, Ziqi Sun, Pei Du, Hua Liu, Yu Zhang, Zheng Zheng, Bingyan Huang, Wenzhao Dong, Suoyi Han, Xinyou Zhang. 2026. Genome-wide characterization and expression analysis of the cultivated peanut AhPR10 gene family mediating resistance to Aspergillus flavus. Journal of Integrative Agriculture, 25(1): 56-67.
https://doi.org/10.1016/j.jia.2024.07.006
Journal of Integrative Agriculture(《农业科学学报(英文)》, JIA)由中华人民共和国农业农村部主管,中国农业科学院与中国农学会主办,中国农业科学院农业信息研究所承办。综合性英文学术期刊,月刊。创刊于2002年,现任主编为中国科学院院士陈化兰。JIA主要栏目有作物科学、园艺、植物保护、动物科学、动物医学、农业生态环境、食品科学、农业经济与管理等。刊稿类型有综述、研究论文、简报以及评述等。全部论文在Elsevier-ScienceDirect (SD) 平台OA出版。最新SCI影响因子4.4,位于SCI-JCR农业综合学科Q1区。中国科学院分区农林科学1区。2016年以来先后获得中国科协等部委 “提升计划”“登峰计划”“卓越计划”项目支持。
Archiver|手机版|科学网 ( 京ICP备07017567号-12 )
GMT+8, 2026-2-22 01:28
Powered by ScienceNet.cn
Copyright © 2007- 中国科学报社